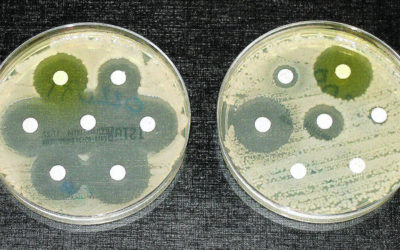
Superbacterias: un peligro real, presente y futuro

Grupo Interacciones Microbianas
Investigación
Grupo de excelencia de Castilla y León
Nosotros
¿Quiénes somos y cómo trabajamos?
Nuestra línea general de investigación refleja el interés actual del grupo en estudiar la biodiversidad microbiana y analizar el potencial de los microorganismos para ser aplicados en diversas facetas biotecnológicas, con especial énfasis en el empleo de bacterias y hongos en la mejora de procesos agroalimentarios y de sostenibilidad ambiental y en la obtención de bioproductos.
Miembros del grupo de investigación
Líneas de trabajo
Actividades de divulgación científica
Noticias
Sección de noticias
De forma periódica se publican noticias de carácter científico y divulgativo relacionadas con el grupo de investigación.
Noticias
“Al virus solo lo derrotamos si la sociedad juega en equipo, sin fisuras”
Variantes, cepas, vacunas, soluciones,… durante la conversación con Raúl Rivas, catedrático del área de Microbiología de la Universidad de Salamanca se van aclarando duda sobre la Covid-19. Ese virus que, de momento, ha venido para quedarse y que ha puesto patas...
Hay que vacunar rápido, si dilatamos la vacunación damos oportunidades al virus para buscar salidas y lo hará mutando
“Hay que vacunar rápido por una razón, y es que si dilatamos la vacunación le damos tiempo al virus a que puedan aparecer nuevas variantes”, explica Raúl Rivas, catedrático del área de Microbiología de la Universidad de Salamanca, añadiendo que vacunarse frente a la...
Superbacterias: un peligro real, presente y futuro
En la actualidad, las bacterias resistentes a los antibióticos son responsables de 700.000 muertes al año. “Llegará un día en que cualquier persona pueda comprar la penicilina en las tiendas. Entonces existirá el peligro de que un hombre ignorante pueda fácilmente...
Dirección
Raúl Rivas: raulrg@usal.es